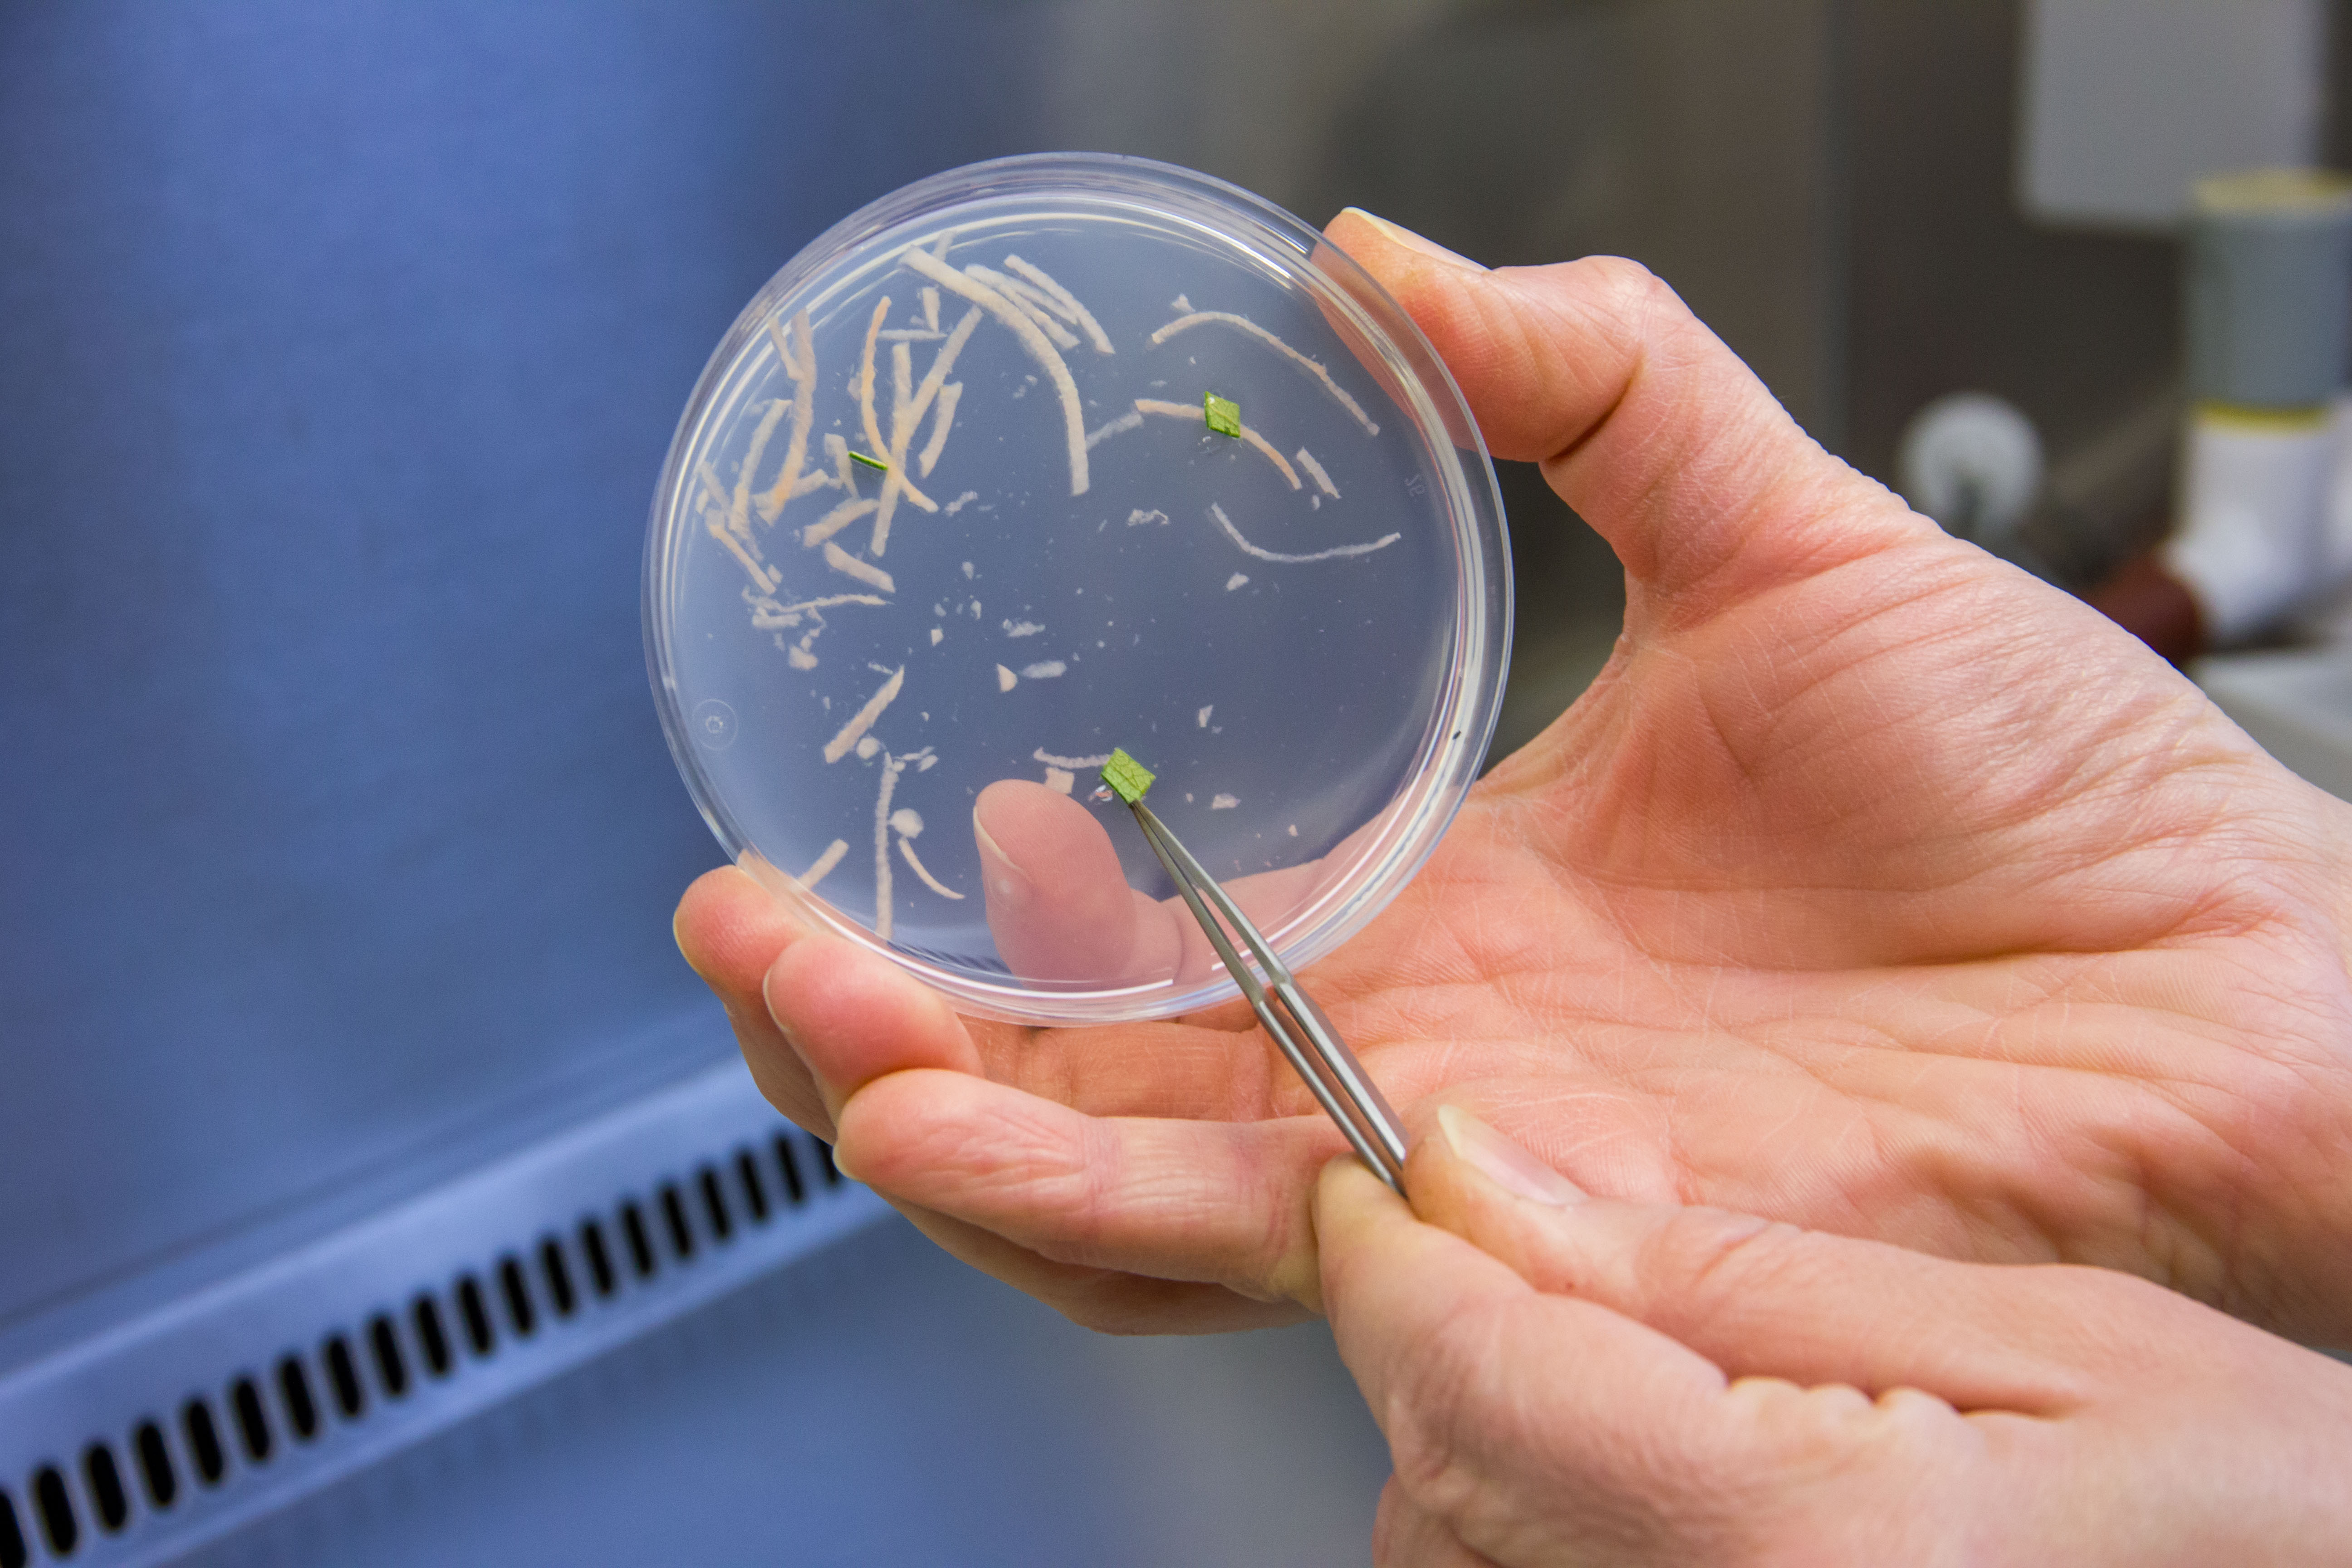

Julius Kühn-Institut, Bundesforschungsinstitut für Kulturpflanzen
Aussteller Woche der Umwelt 2024
Torfersatz ist Klimaschutz – Holz, Gärprodukte und Fasernessel als Alternativen im Gartenbau
Blumenerden und Kultursubstrate basierten bis vor wenigen Jahren zum großen Teil auf Torf. Dieser ist über Jahrtausende aus Torfmoosen in Mooren gewachsen. Werden Moorböden für den Torfabbau entwässert, geben sie jedoch große Mengen CO2 ab. Deshalb soll ab 2030 weitestgehend kein Torf mehr im Erwerbsgartenbau verwendet werden, im Hobbybereich darf Torf bereits ab 2026 nicht mehr eingesetzt werden.Torf ist jedoch schwer zu ersetzen, denn er hat viele Vorteile. Deshalb erforscht das Julius Kühn-Institut Alternativen, die vorzugsweise aus Deutschland bezogen werden können. Ein erfolgversprechender Kandidat sind Holzfasern aus Nadel- oder auch Laubgehölzen. Aber auch Fasernesseln, also Brennnesseln mit erhöhtem Fasergehalt, oder feste Gärrückstände aus Biogasanlagen sind potenziell geeignet, Torf zu ersetzen.
Wir wollen den Besuchenden sowohl die Materialien vorstellen, die als mögliche lokal verfügbare Torfersatzstoffe in Frage kommen, als auch Pflanzenarten wie Rohrkolben, Glanzgras oder Torfmoos zeigen, die auf wiedervernässten Flächen als sogenannte Paludikultur angepflanzt werden können. Hier geht es darum, die wiedergewonnenen Moorflächen ökonomisch sinnvoll zu nutzen, um etwa neue Bau- oder Dämmstoffe zu erzeugen.
Auf dem Weg zum torffreien Gartenbau kommt es auf die richtige Mischung der Torfersatzstoffe an. Denn bisher kann kaum ein Stoff allein Torf ersetzen. Doch Mischungen verschiedener Stoffe können die Eigenschaften des Substrates optimieren. In Greifkästen werden Substratmixe zum Anfassen präsentiert und auch Messmethoden, mit denen sich die Grundeigenschaften wie Nährstoffgehalt, Stickstoffimmobilisierung oder pH-Wert erfassen lassen.
Torfersatzstoffe können mit Krankheitserregern (Pilzen) oder Schadinsekten (Trauermückenlarven) belastet sein. Auch diese Hürden wollen wir erfahrbar machen, indem wir ausgewählte Vertreter der Organismen vorstellen, die den meisten Schaden anrichten. Wir zeigen Schäden an Pflanzen und lebende Vertreter unterm Mikroskop.
Übersicht
Firma
Julius Kühn-Institut, Bundesforschungsinstitut für KulturpflanzenMesseweg 11-12
38104 Braunschweig
Standnr.
98Bilder-Galerie